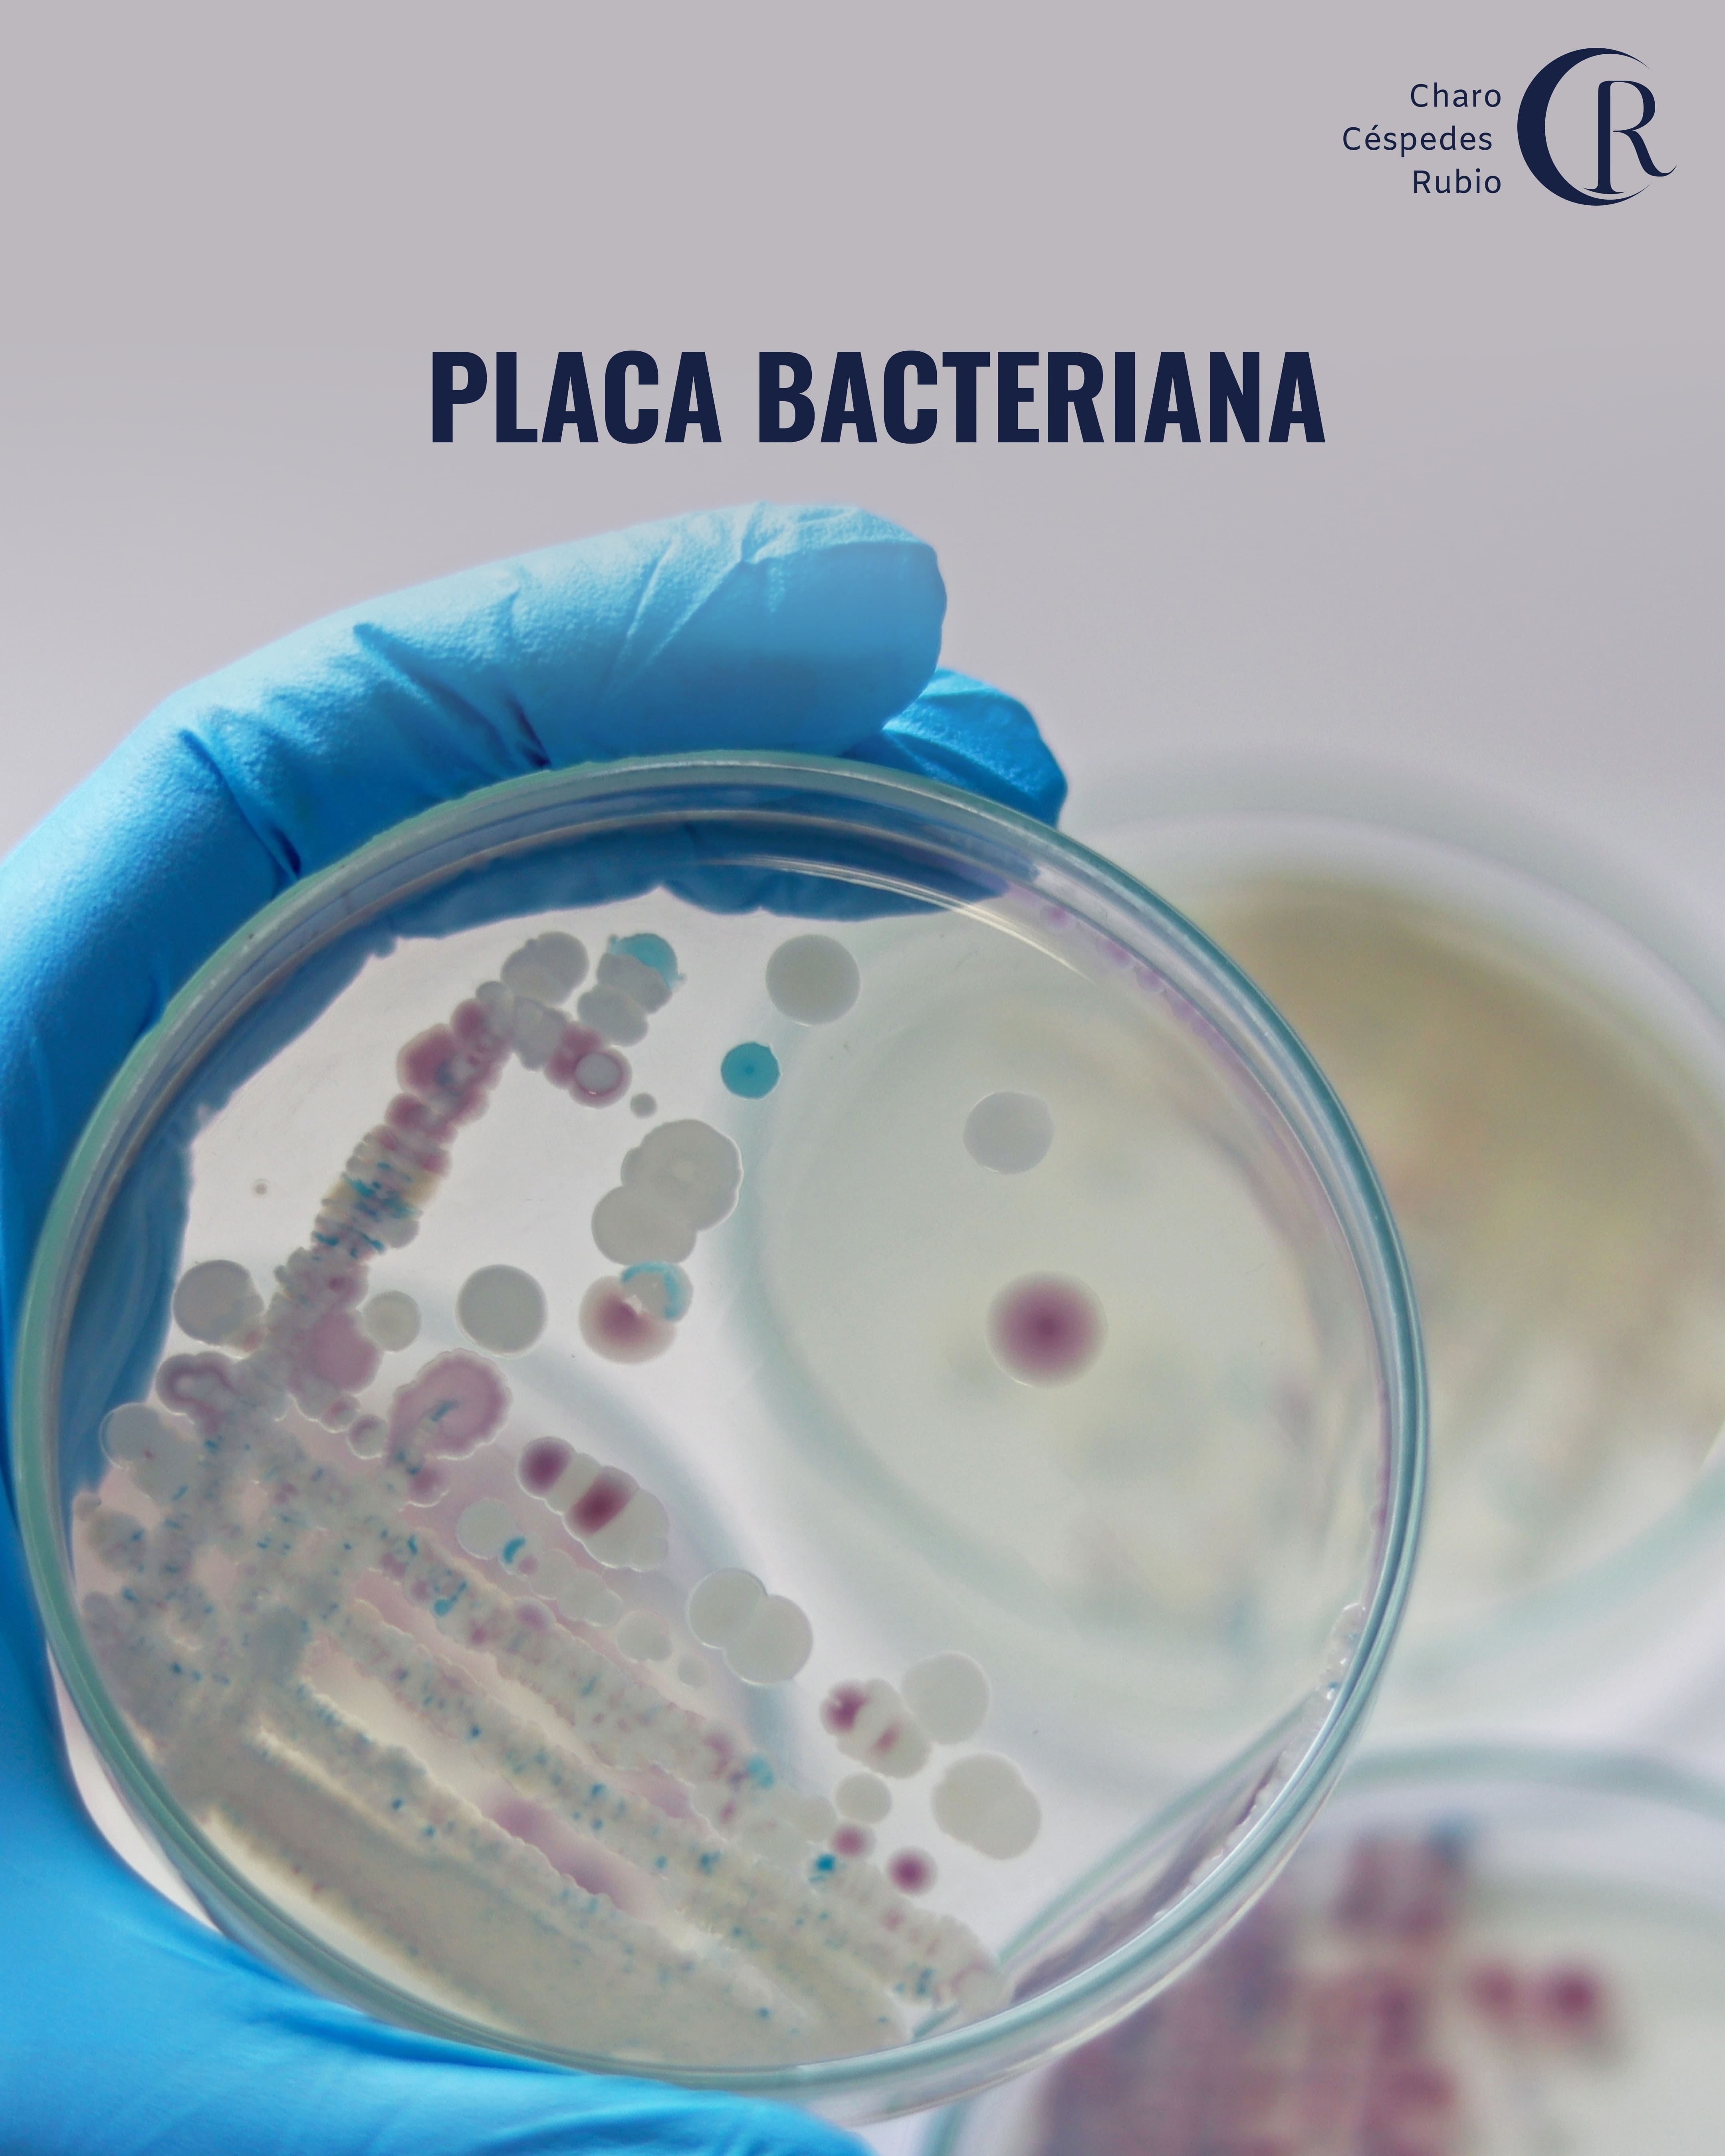

Odontología
Formación de la placa bacteriana

Charo Céspedes Rubio
Biología | Bacteriología y Laboratorio Clínico | Microbiología Clínica
11 nov 2024
¿Sabes cómo se forma la placa bacteriana?
La placa bacteriana se forma por la acumulación excesiva de microorganismos sobre las superficies de la cavidad oral y, si no se controla, da lugar a problemas periodontales..
Esta capa, de textura gelatinosa, se pega a los dientes y se introduce en las fisuras dentales dañando las piezas y la encía. Está formada por más de 200 especies bacterianas, glóbulos blancos y restos alimentarios.
Produce problemas de gingivitis, halitosis, caries y periodontitis.
La naturaleza de la microbiota de la placa dental es fundamental en la etiología y patogénesis de la periodontitis. No solamente el volumen de la placa bacteriana nos indica susceptibilidad o actividad de periodontitis, sino que aún es más importante la flora específica y los factores de virulencia de los microorganismos que la producen.
Te dejo en el carrusel las fases de su formación y más datos importantes.